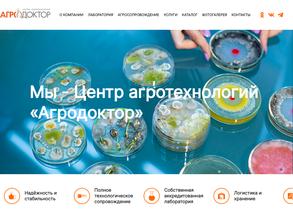
Агродоктор

Санитарно-эпидемиологические исследования в Новосибирске
Центр гигиены и эпидемиологии в Новосибирской области

Адрес: Новосибирск, Лесная, 1а/1, 217 кабинет, 2 этаж
Центр гигиены и эпидемиологии в Новосибирской области

Адрес: Новосибирск, Челюскинцев, 7а к2, 2 этаж
Центр гигиены и эпидемиологии в Новосибирской области
филиал в Искитимском районе
Адрес: Новосибирск, Коммунистическая, 29, 11 офис, 2 этаж
Научно-практический центр охраны труда и сертификации
компания
Адрес: Новосибирск, Ельцовка 1-я, 1 кВ, 2В 2 офис, 2 этаж